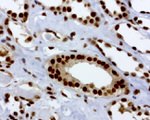
RTRAF Antibody in Immunohistochemistry (Paraffin) (IHC (P))

Search
OriGene
RTRAF Monoclonal Antibody (UMAB181), UltraMAB™
{{$productOrderCtrl.translations['antibody.pdp.commerceCard.promotion.promotions']}}
{{$productOrderCtrl.translations['antibody.pdp.commerceCard.promotion.viewpromo']}}
{{$productOrderCtrl.translations['antibody.pdp.commerceCard.promotion.promocode']}}: {{promo.promoCode}} {{promo.promoTitle}} {{promo.promoDescription}}. {{$productOrderCtrl.translations['antibody.pdp.commerceCard.promotion.learnmore']}}
产品信息
UM800073CF
种属反应
宿主/亚型
分类
类型
克隆号
抗原
偶联物
形式
浓度
纯化类型
保存液
内含物
保存条件
运输条件
产品详细信息
For reconstitution, we recommend adding 100 µL distilled water to a final antibody concentration of about 1 mg/mL. To use this carrier-free antibody for conjugation experiments, we strongly recommend performing another round of desalting. (Zeba Spin Desalting Columns, 7KMWCO, 0.5 mL, Product # 89882)
靶标信息
RTRAF (C14orf166) is an RNA-binding protein involved in modulation of mRNA transcription by Polymerase II (PubMed:16950395). Component of the tRNA-splicing ligase complex and is required for tRNA ligation (PubMed:24870230). May be required for RNA transport (PubMed:24608264).
仅用于科研。不用于诊断过程。未经明确授权不得转售。
篇参考文献 (0)
生物信息学
蛋白别名: CLE; CLE7 homolog; RLL motif containing 1; RNA transcription, translation and transport factor protein
基因别名: C14orf166; CGI-99; CGI99; CLE; CLE7; hCLE1; LCRP369; RLLM1; RTRAF
UniProt ID: (Human) Q9Y224
Entrez Gene ID: (Human) 51637